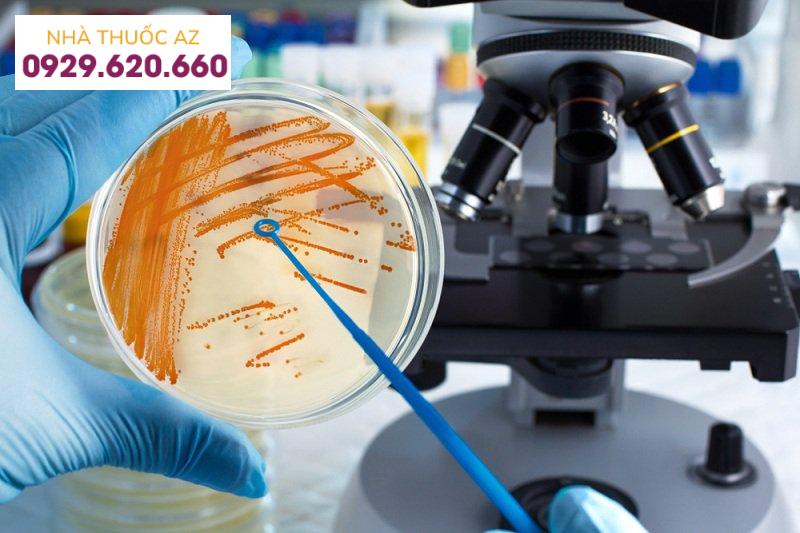
Viêm đại tràng

Viêm đại tràng vi thể là tình trạng viêm đại tràng mãn tính với các triệu chứng tiêu chảy mạn tính nhưng bệnh nhân có hình ảnh nội soi bình thường. Chẩn đoán viêm đại tràng vi thể được dựa trên mô bệnh học.
1. Lịch sử bệnh viêm đại tràng vi thể
Viêm đại tràng vi thể được chia làm hai nhóm, đó là viêm đại tràng collagen và viêm đại tràng lympho.
Bệnh viêm đại tràng collagen đầu tiên được mô tả năm 1976, ở một bệnh nhân tiêu chảy mạn tính được sinh thiết niêm mạc trực tràng. Kết quả sinh thiết ghi nhận có tình trạng lắng đọng collagen dày đặc ở lớp dưới biểu mô. Năm 1980, Read và cộng sự lần đầu sử dụng thuật ngữ “viêm đại tràng vi thể” để mô tả bệnh lý đặc trưng bởi tình trạng tiêu chảy mạn tính và không có màu trong phân. Sau đó, vào năm 1989, Lazenby và cộng sự đã mô tả những đặc điểm về lâm sàng và mô bệnh học của viêm đại tràng lympho. Hai thể bệnh này có nhiều nét tương đồng về đặc điểm lâm sàng và dịch tễ nên được xếp chung vào nhóm viêm đại tràng vi thể.
Theo một nghiên cứu, tỷ lệ mới mắc viêm đại tràng collagen và viêm đại tràng lympho trên 100.000 người hàng năm lần lượt là 4,14 và 4,85. Tỷ lệ hiện mắc viêm đại tràng collagen và viêm đại tràng lympho lần lượt là 49,21 và 63,05 trên 100.000 người. Tỷ lệ mới mắc hai thể bệnh viêm đại tràng này có sự khác biệt theo từng khu vực, nhưng chủ yếu ở châu Âu và châu Mỹ. Tại khu vực châu Á, một số nghiên cứu ở Hàn Quốc ghi nhận tỷ lệ viêm đại tràng collagen ở bệnh nhân tiêu chảy mạn tính là 4%, tương tự như tỷ lệ ở các nước phương Tây nhưng cao hơn so với trong nghiên cứu ở Malaysia và Ấn Độ.
2. Yếu tố nguy cơ gây viêm đại tràng vi thể
2.1. Các bệnh lý tự miễn
Có mối liên quan giữa viêm đại tràng vi thể và các bệnh lý tự miễn như Celiac, viêm đa khớp, bệnh lý tuyến giáp. Có từ 20 – 60% bệnh nhân viêm đại tràng lympho và 17 – 40% bệnh nhân viêm đại tràng collagen có các bệnh lý tự miễn đi kèm theo.Theo một nghiên cứu, có đến 30% bệnh nhân Celiac có hình ảnh của viêm đại tràng vi thể. Khi so sánh với t lệ trong cộng đồng, những bệnh nhân Celiac có tỉ lệ tiến triển thành cao gấp 70 lần, trong đó 64% phát hiện sau khi đã được chẩn đoán Celiac, 11% được chẩn đoán trước và 25% chẩn đoán tại cùng một thời điểm.
2.2. Hút thuốc lá
Trong một nghiên cứu được thực hiện từ năm 2007 – 2010 tại Tây Ban Nha trên 255 bệnh nhân hút thuốc lá cho thấy có sự liên quan chặt chẽ đến viêm đại tràng lympho và viêm đại tràng collagen với OR lần lượt là 3,8 và 2,4.
Một nghiên cứu khác tại Thụy Điển cũng ghi nhận hút thuốc có liên quan đến viêm đại tràng collagen và những người hút thuốc lá xuất hiện bệnh sớm hơn 14 năm so với nhóm không hút thuốc lá. Giả thuyết được đưa ra để giải thích mối liên quan này là hút thuốc lá gây giảm dòng máu đến đại tràng, từ đó làm thay đổi tính thẩm thấu ở niêm mạc đại tràng.2.3. Sử dụng một số loại thuốc.. Nghiên cứu của Beaugeri và cộng sự đã tìm ra mối liên quan của một số loại thuốc với sự xuất hiện của viêm đại tràng vi thể. Một vài báo cáo cũng đã ghi nhận những bệnh nhân cải thiện triệu chứng lâm sàng khi ngừng NSAID và tái phát khi bắt đầu sử dụng lại.
Ngoài ra, sử dụng đồng thời các thuốc ức chế bơm proton (PPI) và NSAID có thể làm tăng nguy cơ tiến triển. Trong số các thuốc thuộc hai nhóm này, diclofenac và omeprazole được báo cáo nhiều nhất.
2.3. Một số yếu tố khác
Viêm đại tràng vi thể hay gặp ở nữ hơn, tuy nhiên một nghiên cứu tại Thụy Điển cho thấy không có mối liên quan giữa nồng độ các hormone sinh dục với viêm đại tràng vi thể.Một vài nghiên cứu đề cập đến vai trò của tình trạng kém hấp thu acid mật. Kết quả mô bệnh học ghi nhận tình trạng teo nhung mao, viêm và lắng đọng collagen ở hồi tràng trong những trường hợp có kém hấp thu acid mật. Một nghiên cứu tại Tây Ban Nha ghi nhận 43% bệnh nhân viêm đại tràng vi thể có kém hấp thu acid mật và hay gặp trong thể viêm đại tràng lympho hơn.

Hút thuốc lá là yếu tố nguy cơ gây viêm đại tràng vi thể.
3. Cơ chế bệnh sinh
Cơ chế bệnh sinh của viêm đại tràng vi thể cho đến nay vẫn chưa thật sự rõ, nhưng một số nghiên cứu thuần tập đã đưa ra giả thuyết liên quan đến các rối loạn điều hòa cơ chế tự miễn hoặc miễn dịch trong quá trình tiếp xúc với các kháng nguyên, đó là một số loại thuốc hoặc vi sinh vật. Sự phơi nhiễm các kháng nguyên kết hợp với rối loạn chức năng hàng rào biểu mô khiến tính thẩm của lớp biểu mô thay đổi và các kháng nguyên có thể tác động vào lớp dưới biểu mô. Sự trùng lặp với Celiac trong bộc lộ các gen HLA gợi ý giả thuyết xảy ra sự thay đổi trong trình diện kháng nguyên ở lớp đệm liên kết của niêm mạc. Cho đến nay, vẫn còn khá ít dữ liệu đề cập đến vai trò của đáp ứng miễn dịch bẩm sinh và trong đó chủ yếu tập trung mô tả sự bất thường của hàng rào bảo vệ ở niêm mạc ruột. Sự tăng nồng độ của các nitric oxide ở niêm mạc đại tràng sẽ tác động đến vùng nối giữa các tế bào biểu mô, từ đó dẫn đến tăng tính thẩm ở khu vực này. Hiện tượng này cũng gặp trong một số bệnh lý viêm khác của đường ruột và được coi là đóng vai trò quan trọng trong cơ chế bệnh sinh.
4. Cơ chế của tiêu chảy trong viêm đại tràng vi thể
Cho đến nay, đã có một số giả thuyết được đưa ra để giải thích cơ chế của tiêu chảy trong viêm đại tràng vi thể, bao gồm:
Sự thay đổi tính thẩm của niêm mạc do quá trình viêm.Tính đa hình của các kênh vận chuyển tái hấp thu serotonin tác động đến nhu động và sự bài tiết của niêm mạc ruột.Tình trạng kém hấp thu acid mật.Các chất trung gian viêm ở lớp màng đệm biểu mô do các kháng nguyên như thuốc, thức ăn, muối mật, vi khuẩn kích hoạt các tế bào lympho.
5. Triệu chứng lâm sàng viêm đại tràng vi thể
Trên lâm sàng, không thể phân biệt được giữa viêm đại tràng collagen và viêm đại tràng lympho. Triệu chứng nổi bật của viêm đại tràng vi thể là tình trạng tiêu chảy mạn tính nhưng không có máu trong phân, bệnh nhân có hình ảnh nội soi dạ dày đại tràng bình thường.
Tiêu chảy mạn tính được định nghĩa là khi tình trạng này kéo dài trên 4 tuần. Phân toàn nước nên sẽ khiến cho bệnh nhân có cảm giác cần đi ngoài lập tức (khoảng 70% bệnh nhân) hoặc đại tiện không tự chủ (khoảng 40% bệnh nhân). Trong những trường hợp nặng, bệnh nhân có thể đi ngoài trên 15 lần/ngày và thường gặp tiêu chảy ban đêm (50% bệnh nhân). Tuy nhiên, tình trạng mất nước nặng, rối loạn điện giải hoặc các biến chứng khác ít gặp. Giai đoạn bệnh tiến triển, bệnh nhân thường bị ảnh hưởng nhiều đến chất lượng cuộc sống. Đau bụng cũng là một triệu chứng hay gặp. Tỷ lệ cảm giác khó chịu hoặc đau quặn bụng có thể lên đến 50%. Chẩn đoán phân biệt giữa viêm đại tràng vi thể với hội chứng ruột kích thích gặp nhiều khó khăn.
Bên cạnh đó, viêm đại tràng vi thể cũng thường hay gặp trong các bệnh lý tự miễn. Theo một nghiên cứu đa trung tâm tại Thụy Điển, tỷ lệ các bệnh lý tự miễn gặp ở 1⁄3 số bệnh nhân viêm đại tràng vi thể, trong đó bao gồm bệnh Celiac (12%), viêm tuyến giáp tự miễn (10.3%), hội chứng Sjogren (3.4%), đái tháo đường (1.7%), các tổn thương tự miễn ở da và khớp (6%). Trong hầu hết các trường hợp, bệnh lý tự miễn được chẩn đoán trước viêm đại tràng vi thể.

Tiêu chảy mạn tính là dấu hiệu phổ biến của bệnh viêm đại tràng.
6. Chẩn đoán cận lâm sàng
Chẩn đoán viêm đại tràng vi thể thường dựa vào khai thác triệu chứng lâm sàng, kết quả mô bệnh học và loại trừ các bệnh lý khác dựa vào hình ảnh nội soi cũng như các phương pháp chẩn đoán hình ảnh khác bình thường. Xét nghiệm của bệnhnhân trong hầu hết các trường hợp đều bình thường hoặc có những thay đổi không đặc hiệu như tăng nhẹ protein phản ứng C, thiếu máu nhẹ. Định nghĩa của viêm đại tràng vi thể là tình trạng viêm đại tràng được chẩn đoán bằng mô bệnh học và bệnh nhân có kết quả nội soi dạ dày đại tràng toàn bộ bình thường, do vậy nội soi đại tràng toàn bộ là bước thăm dò quan trọng trong chẩn đoán bệnh.
Khi tiến hành nội soi cần chú ý để phát hiện các tổn thương niêm mạc đại tràng cũng như sinh thiết nhiều mảnh ở các đoạn đại tràng. Sinh thiết 2 mảnh mỗi đoạn đại tràng được khuyến cáo giúp chẩn đoán mô bệnh học chính xác hơn và lấy sinh thiết ở tất cả các đoạn hữu ích hơn so với chỉ lấy tập trung tại một đoạn.Hình ảnh nội soi dạ dày đại tràng có thể bình thường hoặc gần như bình thường. Với sự phát triển của các kĩ thuật nội soi, các tổn thương ở niêm mạc trong viêm đại tràng vi thể đã ghi nhận và được đánh giá là các bằng chứng ủng hộ cho chẩn đoán.
Một nghiên cứu trên bệnh nhân viêm đại tràng collagen tại Nhật đã báo cáo có đến 80% bệnh nhân tổn thương trên nội soi, bao gồm: Tăng sinh mạch máu, hình thái mạch máu niêm mạc không rõ, vết loét dọc, dầu hiệu “mèo cào”, phù nề từng vùng, niêm mạc lần sần…. Tổn thương niêm mạc dạng vệt chạy dọc đã được ghi nhận ở những bệnh nhân viêm đại tràng collagen có liên quan đến lansoprazole. Đã có ca lâm sàng báo cáo trường hợp viêm đại tràng collagen với tổn thương niêm mạc nặng và có biến chứng.
7. Tiếp cận chẩn đoán viêm đại tràng vi thể
Khai thác bệnh sử:
Khai thác về đặc điểm tiêu chảy, tính chất nhầy máu, tần suất, diễn biến, thời gian tiến triển, tiêu chảy ban đêm, đại tiện không tự chủ.Gầy sút cân.Tiền sử gia đình (IBD, Calia, tổn thương ác tính nội tiết đa ổ).Tiền sử thuốc (lạm dụng thuốc nhuận tràng, tác dụng không mong muốn của thuốc, viêm ruột xạ trị, mổ đường tiêu hóa, cắt túi mật).
Triệu chứng toàn thân:
Chế độ ăn (kém hấp thu lactose, fructosa, sorbitol, Celiac).Tiền sử nghề nghiệp, du lịch, yếu tố phơi nhiễm HIV, nhiễm trùng tái phát dai dẳng.Chế độ ăn (kém hấp thu lactose, fructosa, sorbitol, Celiac).
Đánh giá bệnh nhân với các xét nghiệm:
Cấy phân: Clostridium difficile, cấy phân, soi tươi ký sinh trùng, kháng nguyên phân Giardia.Test huyết thanh: Công thức máu, điện giải đỏ, protein, albumin, tốc độ máu lăng, chức năng tuyến giáp.Test huyết thanh bệnh Celiac.Test không dung nạp lactose.Nội soi và sinh thiết.Mô bệnh học.
Cấy phân là phương pháp chẩn đoán viêm đại tràng vi thể.
8. Điều trị viêm đại tràng vi thể
Điều trị viêm đại tràng vi thể phụ thuộc vào mức độ nặng của các triệu chứng. Mục tiêu điều trị là đẩy lui bệnh, cải thiện chất lượng cuộc sống của bệnh nhân. Trường hợp những bệnh nhân tái phát thường xuyên, việc duy trì đáp ứng điều trị rất cần thiết.
8.1. Tránh các yếu tố nguy cơ
Đây là bước đầu tiên trong quản lý viêm đại tràng vi thể. Cần thảo luận với bệnh nhân về mối liên quan giữa việc hút thuốc lá, sử dụng một số loại thuốc với sự khởi phát và tiến triển bệnh.
8.2. Dùng thuốc Budesonide
Budesonide là thuốc duy nhất có hiệu quả qua các thử nghiệm lâm sàng, có đối chứng. Budesonide là loại corticosteroid có tác động tại chỗ, thuốc được chuyển hóa qua gan, ít tác dụng toàn thân nên rất an toàn.
8.3. Một số lựa chọn điều trị khác
Probiotic: Trong số các thử nghiệm lâm sàng liên quan đến hiệu quả của probiotic đối với viêm đại tràng vi thế, mới chỉ có một thử nghiệm lâm sàng sử dụng Boswellia serrata chứng minh được hiệu quả cải thiện lâm sàng sau 6 tuần.Thuốc chống đi ngoài: Một vài nghiên cứu cho thấy hiệu quả của thuốc loperamide trong việc cải thiện triệu chứng lâm sàng của bệnh, tuy nhiên không có nghiên cứu nào chứng minh về những hiệu quả trong việc đẩy lùi bệnh khi điều trị duy trì.Mesalazine: Trong một thử nghiệm lâm sàng trên bệnh nhân,masala zone liều 2,4g/ngày có hoặc không kết hợp với cholestyramine liều lượng là 4g/ngày, duy trì sử dụng để điều trị trong 6 tháng. Tỷ lệ đẩy lùi bệnh trên lâm sàng và cải thiện mô bệnh học là 85% ở bệnh nhân viêm đại tràng lympho, 91% ở bệnh nhân viêm đại tràng collagen, đặc biệt ở nhóm điều trị phối hợp.Thuốc điều hòa miễn dịch: Azathioprine và 6-mercaptopurine được sử dụng trong những trường hợp bệnh nhân có triệu chứng rất nặng, không đáp ứng hoặc không dung nạp đối với budesonide.Có chế độ dinh dưỡng hợp lý: Trong chế độ dinh dưỡng, người bệnh viêm đại tràng cần tránh ăn các loại thực phẩm cay nóng, thức ăn không đảm bảo vệ sinh an toàn, thức ăn nhanh, thức ăn chứa nhiều hóa chất bảo quản,…. Tuy nhiên, nhiều người cũng thắc mắc về vấn đề “viêm đại tràng có nên ăn sữa chua hay viêm đại tràng uống sữa được không?”. Thực tế, người bị viêm đại tràng vi thể không cần tránh ăn sữa chua, vì nó cung cấp một lượng lợi khuẩn probiotic, giúp ruột hấp thu chất dinh dưỡng tốt hơn.
Tóm lại, viêm đại tràng vi thể có các triệu chứng lâm sàng như tiêu chảy mãn tính, không ra máu, tiêu phân nước. Bệnh có nguồn gốc tự miễn dịch, căn nguyên vẫn chưa rõ ràng. Do đó, mục tiêu điều trị chính là loại bỏ các yếu tố làm trầm trọng thêm bệnh và kiểm soát các triệu chứng.
Để biết thêm các thông tin chi tiết, vui lòng liên hệ với Nhà thuốc AZ theo số hotline 0929 620 660 hoặc truy cập vào website: https://nhathuocaz.com.vn